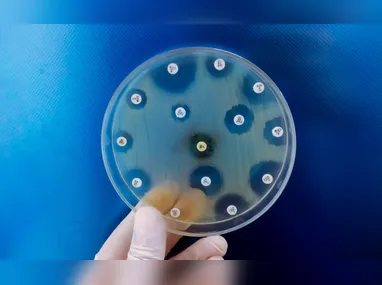
Larissa Dell’Antonio afirmou que a ocorrência da doença está associada a fatores como  idade e histórico familiar

Novembro Azul: conheça sinais do 2º câncer que mais mata homens
Aumento da frequência urinária, especialmente à noite, e alterações no fluxo urinário são alguns sintomas do câncer de próstata

Você sabia que o câncer de próstata é o segundo tipo de câncer que mais afeta homens, atrás apenas do câncer de pele não melanoma? E que ele é também o segundo que mais mata, perdendo somente para o câncer de pulmão? Neste mês, a campanha Novembro Azul ganha vida, conscientizando a população masculina sobre os riscos dessa doença.
A oncologista Juliana Alvarenga Rocha explicou que o câncer de próstata muitas vezes não causa sintomas nos estágios iniciais, o que o torna silencioso e, por isso, um desafio para detecção precoce.
“Quando os sintomas aparecem, eles geralmente estão associados à progressão ou extensão do tumor para além da próstata”, disse.
Alguns sintomas mencionados por ela são o aumento da frequência urinária, especialmente à noite, e alterações no fluxo urinário, com o jato fraco ou intermitente e dificuldade para iniciar ou parar.
Dentre o que é feito para o diagnóstico estão o exame de sangue PSA, que é o teste de Antígeno Prostático Específico, e o toque retal. Neste último, o médico palpa a glândula prostática pela via retal para detectar possível endurecimento ou nodulações.
Se os testes iniciais sugerirem anormalidades, procede-se a exames complementares, como a biópsia, afirmou a médica.
Bruno Costa do Prado, urologista da MedSênior e professor de Medicina da Ufes, explicou que o tratamento da doença localizada se baseia no acompanhamento de casos mais indolores, na cirurgia e na radioterapia.
“Pacientes com a neoplasia em fases mais avançadas precisam realizar hormonioterapia e quimioterapia”.
Larissa Dell’Antonio, enfermeira epidemiologista e referência técnica de Vigilância do Câncer da Secretaria de Saúde (Sesa), afirmou que a ocorrência dessa doença está associada a fatores como a idade e histórico familiar.
“A maioria dos casos ocorre em homens acima de 60 anos, sendo rara sua ocorrência antes dos 40”.
Ela disse também que ainda há preconceito de homens em procurar o serviço de saúde por conta do toque retal.
“O nosso desejo é que os homens vençam essa barreira e que procurem o quanto antes, quando aparecer qualquer sinal de alerta. Com o diagnóstico precoce, o tratamento tem maior chance de cura e melhor qualidade de vida”.
Fique por dentro
Câncer de próstata
O que é?
É um tumor maligno que se desenvolve na próstata. Bruno Costa do Prado, urologista da MedSênior, explicou que ele está principalmente associado ao envelhecimento e a alterações genéticas. Fatores como alimentação inadequada e obesidade também aumentam as chances de aparecimento.
É possível prevenir?
A adoção de um estilo de vida saudável, que inclui uma boa alimentação, a realização de atividades físicas e controle adequado do peso podem diminuir as chances de desenvolver a doença e melhoram a sobrevida de pacientes que já tiveram o diagnóstico e estão em tratamento.
Fatores de risco
A oncologista Juliana Alvarenga Rocha explicou que alguns fatores elevam o risco de desenvolver câncer de próstata. Dentre os principais, estão:
- Idade avançada.
- História familiar: Ter um pai ou irmão com câncer de próstata mais que dobra o risco.
- Etnia/raça: Homens de ascendência africana ou afro-caribenha apresentam risco maior do que homens de ascendência asiática ou hispânica.
- Fatores genéticos: Mutações em genes como BRCA2 ou síndromes como Síndrome de Lynch.
Rastreamento
O Ministério da Saúde e a Organização Mundial da Saúde (OMS) não recomendam que se realize o rastreamento do câncer de próstata, ou seja, não é indicado que homens sem sinais ou sintomas façam exames.
No entanto, homens devem conversar com seus médicos sobre quando iniciar o rastreamento, considerando histórico familiar, etnia e saúde geral. Recomenda-se a investigação a partir dos 45 anos para homens de risco elevado, como ascendência africana, história familiar de câncer de próstata em parente de 1º grau.
E em casos de risco ainda maior (vários parentes com câncer, mutações genéticas conhecidas), alguns guias sugerem investigação ainda mais precoce.
Sintomas
Juliana Alvarenga disse que muitas vezes não há sintoma nos estágios iniciais. Quando aparecem, estão associados à progressão ou extensão do tumor para além da próstata. Alguns deles, são:
- Aumento da frequência urinária, especialmente à noite.
- Alterações no fluxo urinário: jato fraco ou intermitente, dificuldade para iniciar ou parar, sensação de não esvaziar completamente a bexiga.
- Sangue na urina ou no sêmen, embora não sejam específicos.
- Dor persistente nas costas, quadril ou pelve, principalmente se o câncer se espalhar para os ossos.
- Disfunção erétil ou dor ao ejacular, menos frequente, mas possível em estágios mais avançados.
Dados no Estado
De acordo com o boletim epidemiológico sobre o câncer de próstata, produzido pela Vigilância do Câncer, da Coordenação da Vigilância das Doenças e Agravos não Transmissíveis, em 2024 foram 1.223 novos casos de câncer de próstata, sendo que em 2023, foram 1.283.
Já em relação ao número de mortes, dados preliminares do Sistema de Informação de Mortalidade (SIM) apontam que foram registrados, em 2025, até primeira quinzena de outubro, 275 mortes e 358 em 2024, no ano inteiro.
Fonte: Especialistas consultados, Secretaria da Saúde (Sesa) e pesquisa A Tribuna.
MATÉRIAS RELACIONADAS:

Comentários